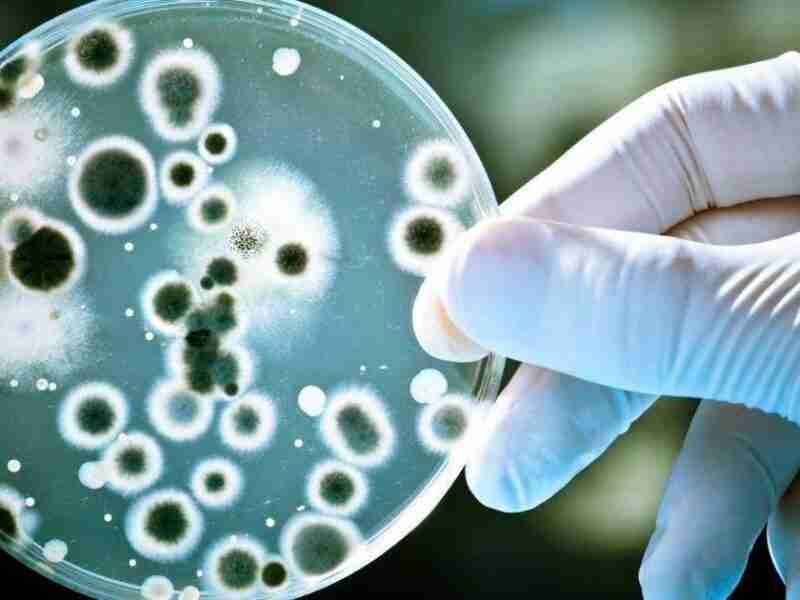

Ahora puedes leer el artículo de La Voz del Muro sobre El experimento de Harvard que muestra la resistencia de las bacterias al antibiótico. Te sorprenderá.
La creciente resistencia de las bacterias a los antibióticos sintéticos y los efectos secundarios derivados de su mal uso, hacen cada vez más frecuente que estos no tengan el efecto deseado.
Así como los antibióticos utilizados racionalmente son indispensables en la medicina, el abuso de…